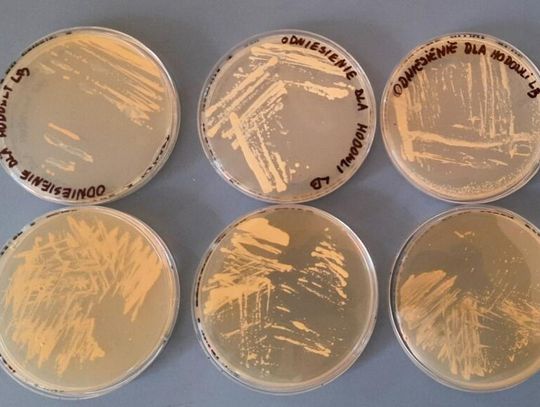

Jesienią tego roku z Centralnego Poligonu Sił Powietrznych w Ustce wystartuje rakieta suborbitalna Perun – pierwszy w pełni polski pojazd tego typu, opracowany przez firmę SpaceForest z Gdyni. Na jej pokładzie znajdzie się nie tylko sprzęt badawczy, ale także coś, co może zaskakiwać: mikroorganizmy z popularnego napoju fermentowanego, znanego jako kombucza.
Za tą niecodzienną misją stoi gdyński start-up AstroFarms, który rozwija biotechnologie mające wspierać przyszłe misje kosmiczne. A wśród młodych naukowców, którzy wzięli udział w projekcie badawczym, znalazł się Marcel Kucypera - mieszkaniec Kędzierzyna-Koźla, absolwent I Liceum Ogólnokształcącego im. Henryka Sienkiewicza, dziś student Międzyuczelnianego Wydziału Biotechnologii Uniwersytetu Gdańskiego i Gdańskiego Uniwersytetu Medycznego.
Projekt, w którym uczestniczy Marcel, nosi nazwę mikroSCO i koncentruje się na badaniu mikroorganizmów żyjących w tzw. SCOBY (Symbiotic Culture of Bacteria and Yeast), czyli symbiotycznej kulturze bakterii i drożdży, wykorzystywanej do fermentacji kombuczy.
Ten pozornie prosty „grzybek do herbaty” okazał się prawdziwą skarbnicą niezwykłych mikrobów, które mogą mieć znaczenie nie tylko dla biotechnologii, ale i przyszłości ludzkiej obecności poza Ziemią.
- W naszych badaniach skupiliśmy się na mikroorganizmach, które potrafią wiązać metale ciężkie, takie jak miedź, ze środowiska. To bardzo ważna cecha, bo metale te w wysokich stężeniach są toksyczne zarówno dla roślin, jak i ludzi - wyjaśnia Marcel.
Jak się okazuje, te same właściwości mogą być niezwykle cenne w kontekście eksploracji kosmosu. Skały na Księżycu i Marsie są bogate w metale, które utrudniają rozwój ziemskiego życia. Jeśli bakterie wyizolowane przez zespół Marcela potrafią neutralizować te pierwiastki, mogą w przyszłości pomóc w tworzeniu środowisk bardziej przyjaznych człowiekowi.
To właśnie te mikroorganizmy zostaną już wkrótce wyniesione w przestrzeń suborbitalną, aby sprawdzić, jak przetrwają w warunkach mikrograwitacji i czy po powrocie na Ziemię ich właściwości pozostaną niezmienione.
Dla Marcela udział w projekcie mikroSCO to spełnienie marzeń i kolejny krok w naukowej drodze. - Od zawsze fascynowała mnie nauka - to, że można szukać odpowiedzi na pytania, na które jeszcze nikt nie zna odpowiedzi. Biotechnologia daje ogromne możliwości łączenia różnych dziedzin - od biologii, przez medycynę, po inżynierię. To sposób, by zrozumieć świat i coś realnie zmieniać - mówi młody badacz.
Zespół, który pracuje na badaniami, liczy pięciu studentów. Ich zadaniem było zaplanowanie i przeprowadzenie całego procesu badawczego – od analizy literatury, przez eksperymenty w laboratorium, aż po interpretację wyników. Nie było to łatwe, bo projekt dotyczył zagadnienia właściwie niezbadanego.
- Były momenty, kiedy nasze próby nie dawały rezultatów. Musieliśmy zmieniać metodologię, szukać nowych rozwiązań, czasem zaczynać od początku. Ale właśnie w tym tkwi piękno nauki - w uporze i odkrywaniu nieznanego - dodaje Marcel.
Podkreśla, że jego sukces nie wziął się znikąd. Fundamentem była dobra edukacja i otwartość, jaką wyniósł z I Liceum Ogólnokształcącego w Kędzierzynie-Koźlu, jednej z wiodących szkół ponadpodstawowych powiatu kędzierzyńsko-kozielskiego.
- Liceum dało mi coś więcej niż wiedzę – nauczyło mnie samodzielności i myślenia krytycznego. Udział w różnych projektach, także społecznych i naukowych, pokazał mi, jak ważne jest łączenie nauki z praktyką. To doświadczenie, które dzisiaj procentuje - wspomina młody naukowiec.
Dzięki tej aktywności już jako uczeń angażował się w inicjatywy edukacyjne i konkursy, współorganizował Noc Biologów czy brał udział w programach naukowych dla młodzieży. Dziś te doświadczenia pomagają mu w pracy badawczej i potwierdzają, że młodzież z mniejszych ośrodków ma ogromny potencjał – wystarczy stworzyć jej przestrzeń do rozwoju.
W korespondencji do zdania młodego naukowca wypowiada się także dyrektor kozielskiego liceum Wojciech Czapla: - Przykład naszego byłego ucznia pokazuje, że w zasadzie nie istnieją bariery naukowe dla naszych absolwentów, oczywiście wiele jest kwestią determinacji i własnego talentu, ale przygotowanie do pójścia własną drogą naukową wszyscy mają jednakowo mocne. Taki sukces zawsze cieszy nie tylko mnie, ale i całą naszą szkolną społeczność.
Start-up AstroFarms, działający w Pomorskim Parku Naukowo-Technologicznym w Gdyni (PPNT Gdynia), specjalizuje się w badaniach nad mikroorganizmami i roślinami w kontekście kosmicznym. Tworzy m.in. napoje probiotyczne AstroBucha™ oraz prowadzi eksperymenty nad hodowlą roślin w symulowanym regolicie – gruncie przypominającym ten z powierzchni Marsa czy Księżyca.
Celem badań jest opracowanie w przyszłości systemów podtrzymywania życia w kosmosie, które pozwolą astronautom produkować żywność i przetwarzać odpady w zamkniętych obiegach biologicznych. Co ciekawe, w ramach tej samej misji badawczej poleci jeszcze pół miliona nasion z firmy Toraf z opolskiego Maciejowa.
Rakieta Perun, wyprodukowana przez firmę SpaceForest z Gdyni, jest natomiast pierwszą polską rakietą suborbitalną zdolną do osiągania granicy kosmosu. Przeszła już testy silnika SF-1000 i ma posłużyć jako mobilna platforma do testowania nowych technologii i eksperymentów naukowych. Misja, w której weźmie udział projekt mikroSCO, to jej pierwszy lot z ładunkiem biologicznym.
Dla Marcela Kucypery to dopiero początek naukowej drogi, ale już dziś jego historia jest inspiracją. Pokazuje, że z pasji i ciekawości można zbudować coś wyjątkowego - nawet jeśli startuje się z niewielkiego miasta.
- To niesamowite uczucie wiedzieć, że coś, nad czym pracowałem, poleci w kosmos. Mam nadzieję, że ten projekt zachęci innych młodych ludzi do szukania swojej drogi w nauce i wierzenia w swoje możliwości - podsumowuje.
Kiedy rakieta Perun wystartuje, wśród jej ładunku znajdzie się także symboliczna cząstka Kędzierzyna-Koźla - udział w przedsięwzięciu młodego naukowca, który udowodnił, że marzenia, wiedza i wytrwałość potrafią naprawdę sięgnąć gwiazd.
Źródło: Starostwo Powiatowe w Kędzierzynie-Koźlu

Napisz komentarz
Komentarze